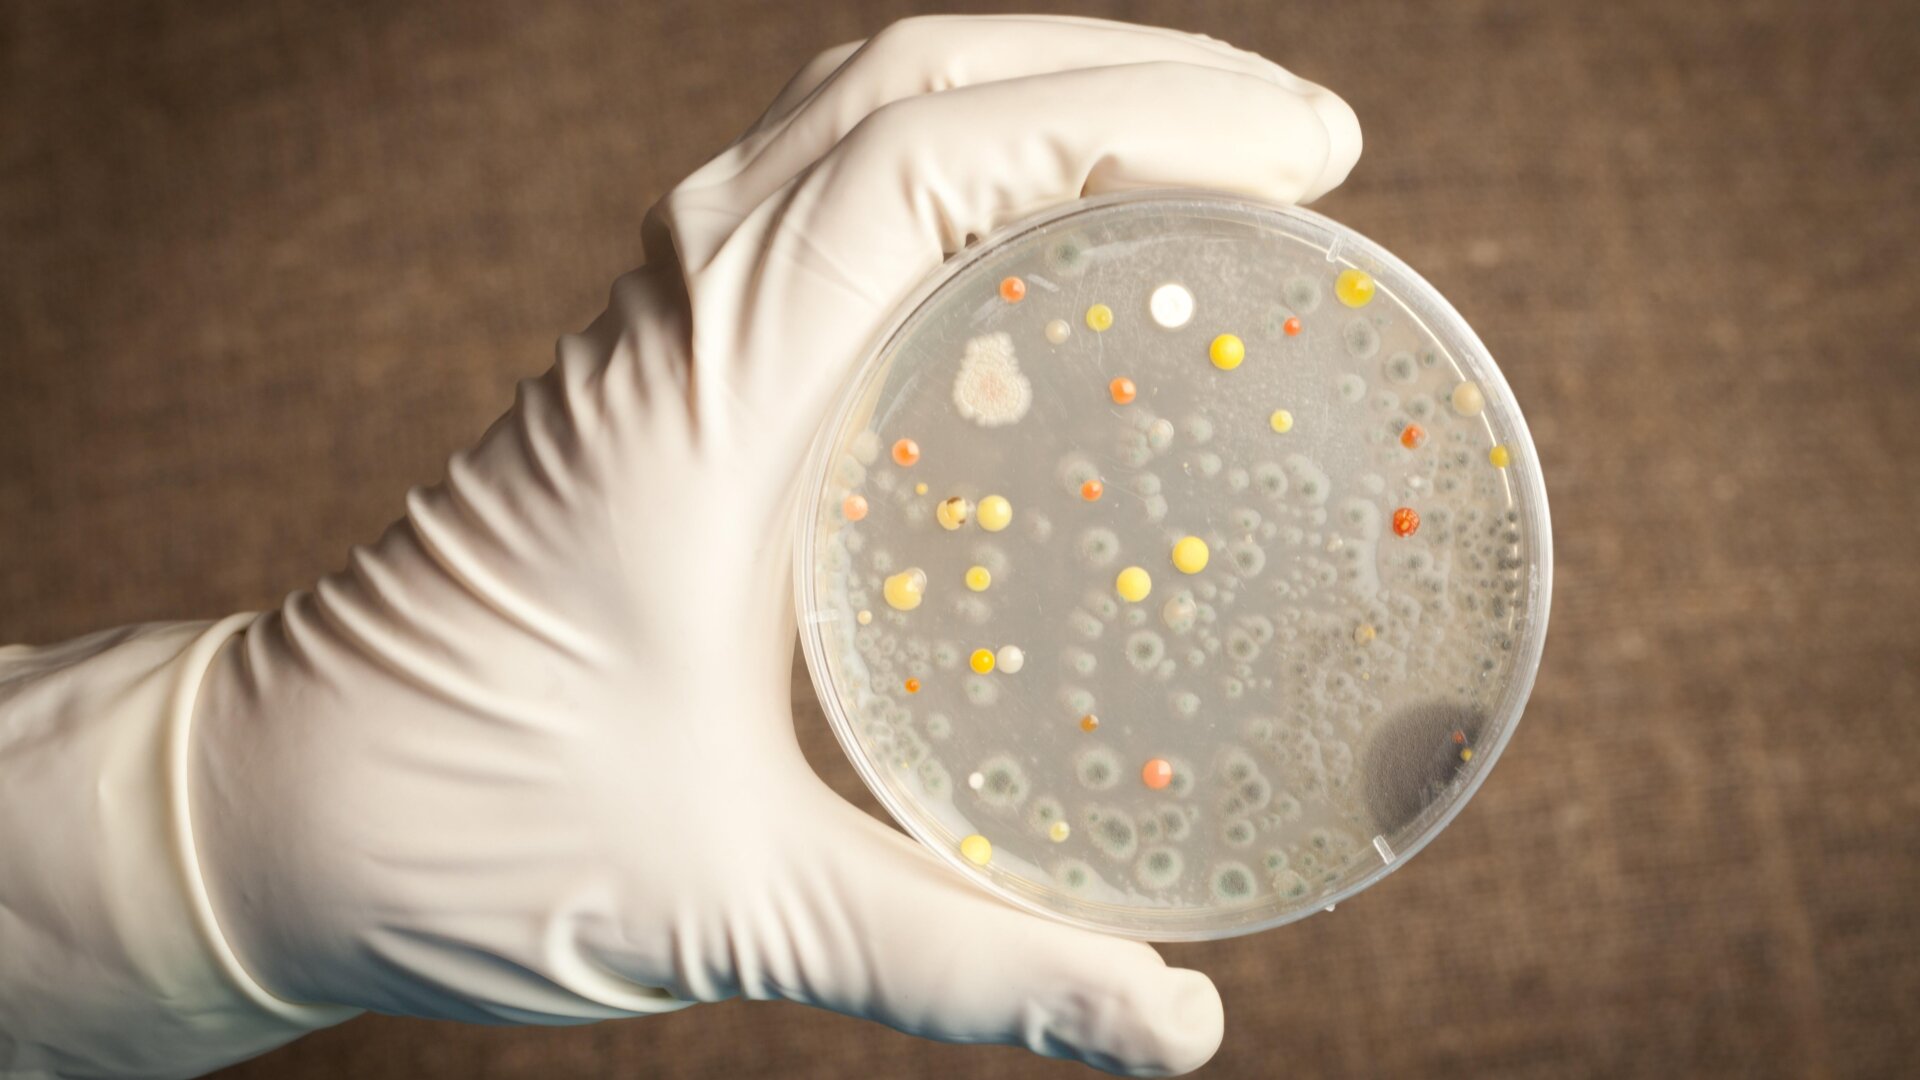
Anthrax bacteria growing on a petri dish.

Anthrax
The infection: Anthrax, caused by the bacteria Bacillus anthracis.
Symptoms and treatment: Its symptoms vary depending on how we’re exposed to the bacteria. When it’s inhaled, it’s often highly fatal. Prompt treatment with antibiotics and antitoxins can prevent or treat serious cases, though.
Threat potential: People usually catch anthrax from infected animals or contaminated animal products. But the ubiquitous presence of anthrax spores in soil provides a constant opportunity for the bacteria to jump into animals. Thankfully, many countries, including the U.S., regularly vaccinate their livestock and a vaccine is available for humans at higher risk of exposure, so cases today are rare. Anthrax still remains a potential bioweapon threat, given its ability to be aerosolized.